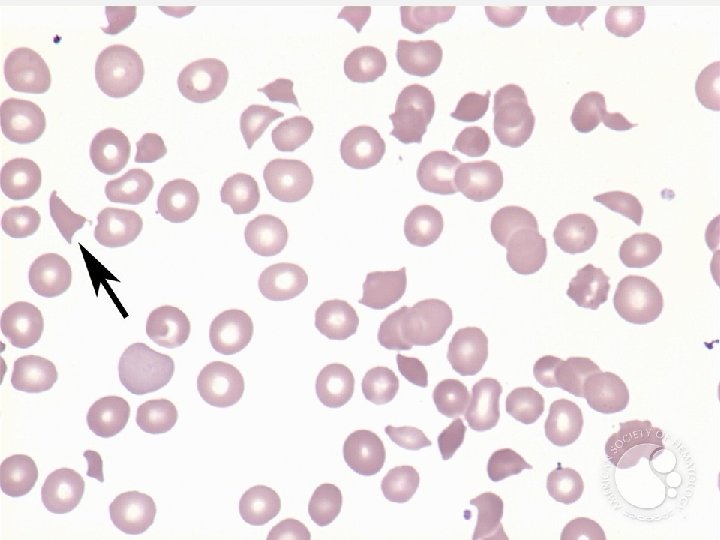

f82d53eb269b74499b5e7e9b92841a2c.ppt
- Количество слайдов: 52
 COMPONENT THERAPY CASE STUDIES Elena Nedelcu, MD Associate Clinical Professor, UCSF Transfusion Medicine 11 -4 -2017
COMPONENT THERAPY CASE STUDIES Elena Nedelcu, MD Associate Clinical Professor, UCSF Transfusion Medicine 11 -4 -2017
 FINANCIAL DISCLOSURE • None
FINANCIAL DISCLOSURE • None
 OBJECTIVES • Present blood component therapy using real patients case studies • Describe the indications, contraindications and recommendations for transfusions for the major blood components • Summarize the medical decision-making process used to determine appropriate therapy for a patient
OBJECTIVES • Present blood component therapy using real patients case studies • Describe the indications, contraindications and recommendations for transfusions for the major blood components • Summarize the medical decision-making process used to determine appropriate therapy for a patient
 CASE 1 • TM request: 1 RBC unit for a 51 yo Caucasian F with chest pain PMHx: • Ischemic cardiomyopathy • Diabetes mellitus • Iron deficiency anemia Allergies: NKDA Labs: • Hb 7. 7 g/d. L • WBC 8. 2 K/micro. L • Plt 250 K/micro. L
CASE 1 • TM request: 1 RBC unit for a 51 yo Caucasian F with chest pain PMHx: • Ischemic cardiomyopathy • Diabetes mellitus • Iron deficiency anemia Allergies: NKDA Labs: • Hb 7. 7 g/d. L • WBC 8. 2 K/micro. L • Plt 250 K/micro. L
 RED BLOOD CELLS Indications: Deficiency of O 2 -carrying capacity or tissue hypoxia due to inadequate circulating RBC mass –Symptomatic anemia Acute or chronic hemorrhage ( >30% of blood volume) Hemolysis Marrow failure Dose: 1 unit will increase Hgb by 1 g/d. L or Hct by 3% 250 -300 m. L: 200 -250 m. L RBCs + 50 m. L plasma Stored 21 -42 days at 1 -6 C Hct 55 -65%
RED BLOOD CELLS Indications: Deficiency of O 2 -carrying capacity or tissue hypoxia due to inadequate circulating RBC mass –Symptomatic anemia Acute or chronic hemorrhage ( >30% of blood volume) Hemolysis Marrow failure Dose: 1 unit will increase Hgb by 1 g/d. L or Hct by 3% 250 -300 m. L: 200 -250 m. L RBCs + 50 m. L plasma Stored 21 -42 days at 1 -6 C Hct 55 -65%
 RED BLOOD CELLS Contraindications: • Acute blood loss <20 -30% blood volume • Crystalloids often adequate • Nutritional anemias or as a substitute for iron or B 12 supplements • Increase colloid osmotic pressure as a volume expander • Improve wound healing or “enhance well-being” • Almost never indicated for Hb ≥ 10 gm/d. L
RED BLOOD CELLS Contraindications: • Acute blood loss <20 -30% blood volume • Crystalloids often adequate • Nutritional anemias or as a substitute for iron or B 12 supplements • Increase colloid osmotic pressure as a volume expander • Improve wound healing or “enhance well-being” • Almost never indicated for Hb ≥ 10 gm/d. L
 CASE 1 (CONT) • TM request: 1 RBC unit approved • Post-transfusion Hb 8. 7 g/d. L • ECG: Normal • Troponin levels: Normal
CASE 1 (CONT) • TM request: 1 RBC unit approved • Post-transfusion Hb 8. 7 g/d. L • ECG: Normal • Troponin levels: Normal
 • 31 RCTs included 12 87 participants • compared restrictive thresholds (transfusion not indicated until the hemoglobin level is 7 -8 g/d. L) with liberal thresholds (transfusion not indicated until the hemoglobin level is 9 -10 g/d. L). JAMA 2016 Nov 15; 316(19): 2025 -2035
• 31 RCTs included 12 87 participants • compared restrictive thresholds (transfusion not indicated until the hemoglobin level is 7 -8 g/d. L) with liberal thresholds (transfusion not indicated until the hemoglobin level is 9 -10 g/d. L). JAMA 2016 Nov 15; 316(19): 2025 -2035
 GOOD CLINICAL PRACTICE STATEMENT • When deciding to transfuse an individual patient, it is good practice to consider • Hemoglobin level • Clinical context • Variables to take into consideration include the rate of decline in hemoglobin level, intravascular volume status, shortness of breath, exercise tolerance, lightheadedness, chest pain thought to be cardiac in origin, hypotension or tachycardia unresponsive to fluid challenge • Patient preferences • Alternative therapies to transfusion Note: This practice guideline is not intended as an absolute standard and will not apply to all individual transfusion decisions.
GOOD CLINICAL PRACTICE STATEMENT • When deciding to transfuse an individual patient, it is good practice to consider • Hemoglobin level • Clinical context • Variables to take into consideration include the rate of decline in hemoglobin level, intravascular volume status, shortness of breath, exercise tolerance, lightheadedness, chest pain thought to be cardiac in origin, hypotension or tachycardia unresponsive to fluid challenge • Patient preferences • Alternative therapies to transfusion Note: This practice guideline is not intended as an absolute standard and will not apply to all individual transfusion decisions.
 RECOMMENDATION 1 • A restrictive RBC transfusion threshold in which the transfusion is not indicated until the hemoglobin level is 7 g/d. L is recommended for hospitalized adult patients who are hemodynamically stable, including critically ill patients, rather than when the hemoglobin level is 10 g/d. L (strong recommendation, moderate quality evidence). • A restrictive RBC transfusion threshold of 8 g/d. L is recommended for patients undergoing orthopedic surgery, cardiac surgery, and those with preexisting cardiovascular disease (strong recommendation, moderate quality evidence). • The restrictive transfusion threshold of 7 g/d. L is likely comparable with 8 g/d. L, but RCT evidence is not available for all patient categories. • Note: These recommendations do not apply to patients with acute coronary syndrome, severe thrombocytopenia (patients treated for hematological or oncological reasons who are at risk of bleeding), and chronic transfusion–dependent anemia (insufficient evidence).
RECOMMENDATION 1 • A restrictive RBC transfusion threshold in which the transfusion is not indicated until the hemoglobin level is 7 g/d. L is recommended for hospitalized adult patients who are hemodynamically stable, including critically ill patients, rather than when the hemoglobin level is 10 g/d. L (strong recommendation, moderate quality evidence). • A restrictive RBC transfusion threshold of 8 g/d. L is recommended for patients undergoing orthopedic surgery, cardiac surgery, and those with preexisting cardiovascular disease (strong recommendation, moderate quality evidence). • The restrictive transfusion threshold of 7 g/d. L is likely comparable with 8 g/d. L, but RCT evidence is not available for all patient categories. • Note: These recommendations do not apply to patients with acute coronary syndrome, severe thrombocytopenia (patients treated for hematological or oncological reasons who are at risk of bleeding), and chronic transfusion–dependent anemia (insufficient evidence).
 CASE 2 • TM request: “ 50 m. L fresh RBCs” for a 1 month old F with a birth weight of 4. 4 kg and Apgar scores of 5, 8 and 9 after 1, 5 and 10 min respectively. It was immediately noticed that the baby had a blueberry muffin appearance and she was in respiratory distress. • Bone marrow study: 66% lymphoblasts, immunophenotypically consistent with a pro-B acute lymphoblastic leukaemia (ALL) (Td. T, HLA-DR and CD 19 positive; CD 10, cytoplasmic l and surface Ig negative; CD 13, CD 15 negative, CD 33 25%). • Cytogenetics and fluorescence in situ hybridization (FISH): 46, XX karyotype and MLL gene rearrangement by t(11; 19)(q 23; p 13).
CASE 2 • TM request: “ 50 m. L fresh RBCs” for a 1 month old F with a birth weight of 4. 4 kg and Apgar scores of 5, 8 and 9 after 1, 5 and 10 min respectively. It was immediately noticed that the baby had a blueberry muffin appearance and she was in respiratory distress. • Bone marrow study: 66% lymphoblasts, immunophenotypically consistent with a pro-B acute lymphoblastic leukaemia (ALL) (Td. T, HLA-DR and CD 19 positive; CD 10, cytoplasmic l and surface Ig negative; CD 13, CD 15 negative, CD 33 25%). • Cytogenetics and fluorescence in situ hybridization (FISH): 46, XX karyotype and MLL gene rearrangement by t(11; 19)(q 23; p 13).
 CASE 2 • Lumbar puncture: No CNS involvement • Status post induction chemotherapy Labs: • Hb 6. 7 g/d. L • WBC 1. 2 K/micro. L • Plt 20 K/micro. L (N: 16. 9 ± 1. 6 g/d. L) (N: 9 -30 K/micro. L) (N: 150 -450 K/micro. L)
CASE 2 • Lumbar puncture: No CNS involvement • Status post induction chemotherapy Labs: • Hb 6. 7 g/d. L • WBC 1. 2 K/micro. L • Plt 20 K/micro. L (N: 16. 9 ± 1. 6 g/d. L) (N: 9 -30 K/micro. L) (N: 150 -450 K/micro. L)
 FRESH VS STANDARD RBCS • 13 RCTs included 5515 participants randomly allocated to receive fresher blood or standard-issue blood • Neonates and infants with very low birth weights and children and adults; most patients had an acute critical illness or surgical hemorrhage. • RCT conducted in North America, South America, Europe, Australia, and Africa compared fresher blood with standard-issue blood • In the 2 primary trials involving neonates, the mean storage durations at the time of transfusion were 1. 6 days and 5. 1 days for fresher RBCs compared with 9. 0 days and 14. 1 days for standard issue RBCs. • The storage duration of the transfused RBCs in the trials of adults ranged from a median of 4 days (mean, 12. 1 days) for fresher RBCs compared with a median of 19 days (mean, 28 days) for standard issue RBCs.
FRESH VS STANDARD RBCS • 13 RCTs included 5515 participants randomly allocated to receive fresher blood or standard-issue blood • Neonates and infants with very low birth weights and children and adults; most patients had an acute critical illness or surgical hemorrhage. • RCT conducted in North America, South America, Europe, Australia, and Africa compared fresher blood with standard-issue blood • In the 2 primary trials involving neonates, the mean storage durations at the time of transfusion were 1. 6 days and 5. 1 days for fresher RBCs compared with 9. 0 days and 14. 1 days for standard issue RBCs. • The storage duration of the transfused RBCs in the trials of adults ranged from a median of 4 days (mean, 12. 1 days) for fresher RBCs compared with a median of 19 days (mean, 28 days) for standard issue RBCs.
 RECOMMENDATION 2 • Patients, including neonates, should receive RBC units selected at any point within their licensed dating period (standard issue) rather than limiting patients to transfusion of only fresh (storage length: <10 days) RBC units (strong recommendation, moderate quality evidence).
RECOMMENDATION 2 • Patients, including neonates, should receive RBC units selected at any point within their licensed dating period (standard issue) rather than limiting patients to transfusion of only fresh (storage length: <10 days) RBC units (strong recommendation, moderate quality evidence).
 EVIDENCE SUMMARY (CONT) • No evidence that transfusion of fresher RBCs is superior to standard issue RBCs for the outcome of mortality (RR, 1. 04; 95% CI, 0. 95 -1. 14) with similar estimates in both adults and infants • The RCT quality assessment found no serious risk of bias, inconsistency, indirectness, or publication bias. • The overall quality of RCT evidence was moderate for 30 -day mortality because the 95% CI included an important decrease in deaths with fresher blood.
EVIDENCE SUMMARY (CONT) • No evidence that transfusion of fresher RBCs is superior to standard issue RBCs for the outcome of mortality (RR, 1. 04; 95% CI, 0. 95 -1. 14) with similar estimates in both adults and infants • The RCT quality assessment found no serious risk of bias, inconsistency, indirectness, or publication bias. • The overall quality of RCT evidence was moderate for 30 -day mortality because the 95% CI included an important decrease in deaths with fresher blood.
 EVIDENCE SUMMARY (CONT) • No evidence to suggest that patients had more adverse events by receiving standard issue RBCs • However, the quality of the evidence was low. • For nosocomial infections, there was a higher risk of infection among patients receiving fresher RBCs with an absolute difference of 43 more nosocomial infections/1000 patients transfused (95% CI, 1 more nosocomial infection to 86 more nosocomial infections/1000). • The absolute difference in 30 -day mortality was 4 more deaths per 1000 with fresher blood (95% CI, 5 fewer deaths to 14 more deaths per 1000).
EVIDENCE SUMMARY (CONT) • No evidence to suggest that patients had more adverse events by receiving standard issue RBCs • However, the quality of the evidence was low. • For nosocomial infections, there was a higher risk of infection among patients receiving fresher RBCs with an absolute difference of 43 more nosocomial infections/1000 patients transfused (95% CI, 1 more nosocomial infection to 86 more nosocomial infections/1000). • The absolute difference in 30 -day mortality was 4 more deaths per 1000 with fresher blood (95% CI, 5 fewer deaths to 14 more deaths per 1000).
 SUMMARY For RBC transfusion thresholds: • The summary estimates across trials demonstrated that restrictive RBC transfusion thresholds were not associated with higher rates of adverse clinical outcomes (30 -day mortality, myocardial infarction, cerebrovascular accident, rebleeding, pneumonia, or thromboembolism). For RBC storage duration: • RCTs demonstrated that fresher blood did not improve clinical outcomes.
SUMMARY For RBC transfusion thresholds: • The summary estimates across trials demonstrated that restrictive RBC transfusion thresholds were not associated with higher rates of adverse clinical outcomes (30 -day mortality, myocardial infarction, cerebrovascular accident, rebleeding, pneumonia, or thromboembolism). For RBC storage duration: • RCTs demonstrated that fresher blood did not improve clinical outcomes.
 RECOMMENDATION 2 • No evidence that the transfusion of fresher blood decreased mortality compared with standard-issue blood. However, the RBC storage duration trials did not evaluate: • patients undergoing a massive or exchange transfusion; • neonates and children with underlying renal disease at higher risk of hyperkalemia • patients undergoing intrauterine transfusions; or • patients with hemoglobinopathies requiring chronic transfusion support.
RECOMMENDATION 2 • No evidence that the transfusion of fresher blood decreased mortality compared with standard-issue blood. However, the RBC storage duration trials did not evaluate: • patients undergoing a massive or exchange transfusion; • neonates and children with underlying renal disease at higher risk of hyperkalemia • patients undergoing intrauterine transfusions; or • patients with hemoglobinopathies requiring chronic transfusion support.
 CASE 2 (FOLLOW-UP) • 50 m. L aliquot of irradiated CMV-negative 5 day-old RBCs • Post-transfusion Hb 8. 5 g/d. L
CASE 2 (FOLLOW-UP) • 50 m. L aliquot of irradiated CMV-negative 5 day-old RBCs • Post-transfusion Hb 8. 5 g/d. L
 SPECIAL REQUIREMENTS CMV negative RBCs • Blood donor is seronegative for CMV • Indications: • Premature infants (<1200 gms) born to CMV-negative mothers • CMV-negative pregnant women • CMV-negative bone marrow and hematopoietic progenitor cell or solid organ transplant recipients • CMV-seronegative patients who are severely immunosuppressed
SPECIAL REQUIREMENTS CMV negative RBCs • Blood donor is seronegative for CMV • Indications: • Premature infants (<1200 gms) born to CMV-negative mothers • CMV-negative pregnant women • CMV-negative bone marrow and hematopoietic progenitor cell or solid organ transplant recipients • CMV-seronegative patients who are severely immunosuppressed
 SPECIAL REQUIREMENTS Irradiated RBCs exposed to cesium-137 or cobalt-60 Prevents proliferation of donor T lymphocytes Indications - Prevention of transfusion-associated GVHD • Intrauterine transfusion • Congenital immunodeficiencies • Infant <4 months old • Recipients of blood from 1 st degree relatives or HLA-matched units • Bone marrow or stem cell transplant recipients; • Hodgkin’s disease
SPECIAL REQUIREMENTS Irradiated RBCs exposed to cesium-137 or cobalt-60 Prevents proliferation of donor T lymphocytes Indications - Prevention of transfusion-associated GVHD • Intrauterine transfusion • Congenital immunodeficiencies • Infant <4 months old • Recipients of blood from 1 st degree relatives or HLA-matched units • Bone marrow or stem cell transplant recipients; • Hodgkin’s disease
 IRRADIATION (CONT) NOT indicated in: • HIV • Hemophilia • Term neonates on ECMO • Small volume transfusions in term infants • Elderly patients • Immunocompetent surgical patients • Pregnancy • Sickle cell disease • Patients with most solid tumors
IRRADIATION (CONT) NOT indicated in: • HIV • Hemophilia • Term neonates on ECMO • Small volume transfusions in term infants • Elderly patients • Immunocompetent surgical patients • Pregnancy • Sickle cell disease • Patients with most solid tumors
 SPECIAL REQUIREMENTS Leukocyte reduced RBCs - Reduced risk of: • Febrile transfusion reactions • HLA alloimmunization • CMV safe (equivalent to CMV seronegative units with regard to risk of CMV transmission) Washed RBCs • 99% of plasma is removed • Shelf life of 24 h after washing Indications: • History of severe or frequent allergic transfusion reactions • Ig. A deficiency • Hyperkalemia, especially in a child or infant
SPECIAL REQUIREMENTS Leukocyte reduced RBCs - Reduced risk of: • Febrile transfusion reactions • HLA alloimmunization • CMV safe (equivalent to CMV seronegative units with regard to risk of CMV transmission) Washed RBCs • 99% of plasma is removed • Shelf life of 24 h after washing Indications: • History of severe or frequent allergic transfusion reactions • Ig. A deficiency • Hyperkalemia, especially in a child or infant
 CASE 3 • TM request: 1 apheresis platelets for a 30 yo F with thrombocytopenia, fatigue and altered mental status, no signs of bleeding PMHx: • Unremarkable • Allergies: NKDA Labs: • Hb 6. 7 g/d. L, WBC 9. 2 K/micro. L, plt 25 K/micro. L
CASE 3 • TM request: 1 apheresis platelets for a 30 yo F with thrombocytopenia, fatigue and altered mental status, no signs of bleeding PMHx: • Unremarkable • Allergies: NKDA Labs: • Hb 6. 7 g/d. L, WBC 9. 2 K/micro. L, plt 25 K/micro. L
CASE 3 (CONT) Thrombotic thrombocytopenic purpura (TTP) • Fever • Microangiopathic hemolytic anemia • Thrombocytopenia • Renal dysfunction (insufficiency) • Neurological symptoms (altered mental status -> coma) • Schistocytes on PBS!! • Also seen in valvular disease, disseminated intravascular coagulation, severe burns Follow-up: • TM request not approved. • Therapeutic plasma exchange initiated daily, patient improved.
CASE 3 (CONT) Thrombotic thrombocytopenic purpura (TTP) • Fever • Microangiopathic hemolytic anemia • Thrombocytopenia • Renal dysfunction (insufficiency) • Neurological symptoms (altered mental status -> coma) • Schistocytes on PBS!! • Also seen in valvular disease, disseminated intravascular coagulation, severe burns Follow-up: • TM request not approved. • Therapeutic plasma exchange initiated daily, patient improved.
 PLASMA PRODUCTS • FFP/FP 24 = 200 -250 m. L • Apheresis (“Jumbo”) Plasma = 500 -600 m. L Dose: • ~ 10 -15 ml/kg body weight • Therapy is guided by coagulation studies (PT, a. PTT) Contains all clotting factors • 1 m. L contains 1 unit of coagulation factor activity • No RBCs, no platelets, no WBCs
PLASMA PRODUCTS • FFP/FP 24 = 200 -250 m. L • Apheresis (“Jumbo”) Plasma = 500 -600 m. L Dose: • ~ 10 -15 ml/kg body weight • Therapy is guided by coagulation studies (PT, a. PTT) Contains all clotting factors • 1 m. L contains 1 unit of coagulation factor activity • No RBCs, no platelets, no WBCs
 TYPES OF PLASMA PRODUCTS • Fresh Frozen Plasma (FFP) • Plasma frozen within 24 hours after phlebotomy (FP 24, PF 24) • Plasma frozen within 24 hours after phlebotomy held at room temperature up to 24 hours after phlebotomy (PF 24 RT 24) • Thawed Plasma (TP) • FP 24, PF 24 RT 24 and TP: Clotting factor levels comparable to FFP • Liquid Plasma • Retains at least 50% of clotting factor levels for 15 days
TYPES OF PLASMA PRODUCTS • Fresh Frozen Plasma (FFP) • Plasma frozen within 24 hours after phlebotomy (FP 24, PF 24) • Plasma frozen within 24 hours after phlebotomy held at room temperature up to 24 hours after phlebotomy (PF 24 RT 24) • Thawed Plasma (TP) • FP 24, PF 24 RT 24 and TP: Clotting factor levels comparable to FFP • Liquid Plasma • Retains at least 50% of clotting factor levels for 15 days
 FFP INDICATIONS • 80 RCTs investigated FP • No consistent evidence of significant benefit for prophylactic and therapeutic use across a range of indications evaluated. Yang L et al. Is fresh-frozen plasma clinically effective? An update of a systematic review of randomized controlled trials. Transfusion 2012; 52: 1673 -1686
FFP INDICATIONS • 80 RCTs investigated FP • No consistent evidence of significant benefit for prophylactic and therapeutic use across a range of indications evaluated. Yang L et al. Is fresh-frozen plasma clinically effective? An update of a systematic review of randomized controlled trials. Transfusion 2012; 52: 1673 -1686
 FFP INDICATIONS • Coagulopathy due to multiple factor deficiencies • Liver disease • Emergent reversal of nutritional Vit K deficiency or Warfarin overdose • Correction of dilutional coagulopathy in massive transfusion • Replacement of coagulation factors when PT/PTT > 1. 5 x N • Plasma exchange for TTP • Documented deficiency of plasma coagulation factors with bleeding or risk of bleeding when specific factor concentrates are not available (eg. , Protein C, Protein S, FII, V, X and XI) • Patient with C 1 esterase inhibitor deficiency (hereditary angioedema) when recombinant therapy is not available
FFP INDICATIONS • Coagulopathy due to multiple factor deficiencies • Liver disease • Emergent reversal of nutritional Vit K deficiency or Warfarin overdose • Correction of dilutional coagulopathy in massive transfusion • Replacement of coagulation factors when PT/PTT > 1. 5 x N • Plasma exchange for TTP • Documented deficiency of plasma coagulation factors with bleeding or risk of bleeding when specific factor concentrates are not available (eg. , Protein C, Protein S, FII, V, X and XI) • Patient with C 1 esterase inhibitor deficiency (hereditary angioedema) when recombinant therapy is not available
 FFP CONTRAINDICATIONS • Volume expansion • Protein source • When coagulopathy can be corrected with specific therapy • Vitamin K • Factor concentrates • Normalizing abnormal coag results, in the absence of bleeding
FFP CONTRAINDICATIONS • Volume expansion • Protein source • When coagulopathy can be corrected with specific therapy • Vitamin K • Factor concentrates • Normalizing abnormal coag results, in the absence of bleeding
 DOSE REQUIREMENTS • Depends on clinical situation • For replacement of coagulation factors: • 10 -20 m. L/kg (approximately 3 -6 units) • Should level of coag factors by 20% • Monitor by measurement of PT/INR, PTT and clinically
DOSE REQUIREMENTS • Depends on clinical situation • For replacement of coagulation factors: • 10 -20 m. L/kg (approximately 3 -6 units) • Should level of coag factors by 20% • Monitor by measurement of PT/INR, PTT and clinically
 PLATELET PRODUCTS • WB-Derived Platelet • Apheresis Platelet • 50 -70 m. L plasma • 200 -400 m. L plasma • Contains WBCs, some RBCs • Contains minimal RBCs • Plt count by 5 -10, 000/µL • Plt count by 30 -40, 000/µL • Usually pooled • Obtained from a single donor • Dose: One unit at a time • 10 -15 m. L/kg or 1 unit/10 Kg • Usually 6 -8 units for an adult
PLATELET PRODUCTS • WB-Derived Platelet • Apheresis Platelet • 50 -70 m. L plasma • 200 -400 m. L plasma • Contains WBCs, some RBCs • Contains minimal RBCs • Plt count by 5 -10, 000/µL • Plt count by 30 -40, 000/µL • Usually pooled • Obtained from a single donor • Dose: One unit at a time • 10 -15 m. L/kg or 1 unit/10 Kg • Usually 6 -8 units for an adult
 INDICATIONS FOR PLATELETS Thrombocytopenia <10, 000 Prophylactic transfusions* <20, 000 if febrile or septic <50, 000 if bleeding or undergoing procedure/major surgery <100, 000 for neurosurgery, ophthalmologic procedures, liver, lung, kidney etc Thrombocytopathy Congenital defects Drugs (ASA, Plavix) External agents (cardiac bypass or ECMO) *Kaufman RM et al. Ann Intern Med 2015; 162: 205 -13 Nahirniak S et al. Transfus Med Rev 2015; 29: 3 -13
INDICATIONS FOR PLATELETS Thrombocytopenia <10, 000 Prophylactic transfusions* <20, 000 if febrile or septic <50, 000 if bleeding or undergoing procedure/major surgery <100, 000 for neurosurgery, ophthalmologic procedures, liver, lung, kidney etc Thrombocytopathy Congenital defects Drugs (ASA, Plavix) External agents (cardiac bypass or ECMO) *Kaufman RM et al. Ann Intern Med 2015; 162: 205 -13 Nahirniak S et al. Transfus Med Rev 2015; 29: 3 -13
 RISK OF MAJOR BLEEDING Plt Count Risk of Hemorrhage Transfuse only for neurosurgical or ophthalmic procedures >50, 000/u. L Bleeding with surgery, invasive procedures not likely < 50, 000/u. L Spontaneous bleeding unlikely but may occur with surgery or trauma Transfuse if bleedin <10, 000/u. L Risk of spontaneous bleeding Prophylactic Transfusion <5, 000/u. L High risk of spontaneous bleeding
RISK OF MAJOR BLEEDING Plt Count Risk of Hemorrhage Transfuse only for neurosurgical or ophthalmic procedures >50, 000/u. L Bleeding with surgery, invasive procedures not likely < 50, 000/u. L Spontaneous bleeding unlikely but may occur with surgery or trauma Transfuse if bleedin <10, 000/u. L Risk of spontaneous bleeding Prophylactic Transfusion <5, 000/u. L High risk of spontaneous bleeding
 CONTRAINDICATIONS FOR PLATELETS Absolute: • TTP/HUS (Unless life-threatening bleeding is present) Relative: • Heparin-induced thrombocytopenia (HIT) • Immune thrombocytopenic purpura (ITP) • Uremia-related platelet dysfunction - not useful. Treat with: • DDAVP or Cryoprecipitate • RBC transfusion (keep HCT 30%)
CONTRAINDICATIONS FOR PLATELETS Absolute: • TTP/HUS (Unless life-threatening bleeding is present) Relative: • Heparin-induced thrombocytopenia (HIT) • Immune thrombocytopenic purpura (ITP) • Uremia-related platelet dysfunction - not useful. Treat with: • DDAVP or Cryoprecipitate • RBC transfusion (keep HCT 30%)
 CASE 4 • TM request: FFP for 63 yo M with a PMHx of atrial fibrillation, ischemic cardiomyopathy and two DVT/PE episodes on Warfarin is admitted for scheduled aortocoronary bypass • Labs: • Hb 9. 6 g/d. L, INR 3. 5
CASE 4 • TM request: FFP for 63 yo M with a PMHx of atrial fibrillation, ischemic cardiomyopathy and two DVT/PE episodes on Warfarin is admitted for scheduled aortocoronary bypass • Labs: • Hb 9. 6 g/d. L, INR 3. 5
 FFP FOR WARFARIN REVERSAL • Goal: INR of 1. 3 -1. 5 • Reversal time • Intravenous vitamin K - 24 -38 h • Plasma - 6 -24 h • 4 -factor prothrombin complex concentrates (PCCs)-less than 1 h Menzin J et al. J Thromb Haemost 2012; 10: 596 -605 Bhatia M et al. Ann R Coll Surg Engl 2010; 92: 473 -476
FFP FOR WARFARIN REVERSAL • Goal: INR of 1. 3 -1. 5 • Reversal time • Intravenous vitamin K - 24 -38 h • Plasma - 6 -24 h • 4 -factor prothrombin complex concentrates (PCCs)-less than 1 h Menzin J et al. J Thromb Haemost 2012; 10: 596 -605 Bhatia M et al. Ann R Coll Surg Engl 2010; 92: 473 -476
 Volume FFP needed to reverse Initial INR Plasma (m. L/kg) (units) For 225 m. L/unit & BW of 70 kg 1. 5 -1. 9 1 3. 2 2 -3 2 6. 4 3 -4 3 9. 6 4 -8 4 12. 9 • Intravenous vitamin K - 0. 5 m. L • 4 -factor prothrombin complex concentrates (PCCs) • 1 m. L/kg for INR of 2 -4 • 2 m. L/kg for INR > 6 Fakheri RJ. Mayo Clin Proc 2013; 88: 640 Kcentra package insert, Sep 2014
Volume FFP needed to reverse Initial INR Plasma (m. L/kg) (units) For 225 m. L/unit & BW of 70 kg 1. 5 -1. 9 1 3. 2 2 -3 2 6. 4 3 -4 3 9. 6 4 -8 4 12. 9 • Intravenous vitamin K - 0. 5 m. L • 4 -factor prothrombin complex concentrates (PCCs) • 1 m. L/kg for INR of 2 -4 • 2 m. L/kg for INR > 6 Fakheri RJ. Mayo Clin Proc 2013; 88: 640 Kcentra package insert, Sep 2014
 CASE 4 (CONT) • 3 FFP transfused • Follow-up INR: 1. 6 • ACB successfully performed, no post-op bleeding
CASE 4 (CONT) • 3 FFP transfused • Follow-up INR: 1. 6 • ACB successfully performed, no post-op bleeding
 CASE 5 • TM request: 1 RBC for 71 yo AA M with diabetes mellitus, alcoholic cirrhosis and renal insufficiency on hemodialysis status presents with hematemesis Labs: • Hb 7. 5 g/d. L Hct 23% WBC 9. 5 K/micro. L, Plt 70 K/micro. L • PT 17 sec (N: 12 -14. 7 sec) • a. PTT 40 sec (N: 22. 9 -35. 8 sec) • TT 30 sec (N: 15. 0 -21. 2 sec) • Fibrinogen 80 mg/d. L (N: 230 -510 mg/d. L)
CASE 5 • TM request: 1 RBC for 71 yo AA M with diabetes mellitus, alcoholic cirrhosis and renal insufficiency on hemodialysis status presents with hematemesis Labs: • Hb 7. 5 g/d. L Hct 23% WBC 9. 5 K/micro. L, Plt 70 K/micro. L • PT 17 sec (N: 12 -14. 7 sec) • a. PTT 40 sec (N: 22. 9 -35. 8 sec) • TT 30 sec (N: 15. 0 -21. 2 sec) • Fibrinogen 80 mg/d. L (N: 230 -510 mg/d. L)
 CASE 5 (CONT) Follow-up: • 1 RBC approved • Cryoprecipitate recommended: • Dose= (Desired fibrinogen increment x PV)/250 • = [(100 -80) x (1 -0. 23) x 70]/250 = 1078/250 = 4. 3 • 5 units approved
CASE 5 (CONT) Follow-up: • 1 RBC approved • Cryoprecipitate recommended: • Dose= (Desired fibrinogen increment x PV)/250 • = [(100 -80) x (1 -0. 23) x 70]/250 = 1078/250 = 4. 3 • 5 units approved
 CRYOPRECIPITATE • Made from 1 unit partially thawed FFP • Contains: Fibrinogen, factor VIII (min 80 U/unit), v. WF, factor XIII • Stored 1 year frozen, 6 hours thawed • Dose: Adult: One dose: 8 -10 bags (10 -20 at one time) Children: 1 -2 bags/10 Kg • One dose increases the Fibrinogen by 5 -10 mg/d. L in an average -size adult • In bleeding patient, target fibrinogen is at least 100 mg/d. L
CRYOPRECIPITATE • Made from 1 unit partially thawed FFP • Contains: Fibrinogen, factor VIII (min 80 U/unit), v. WF, factor XIII • Stored 1 year frozen, 6 hours thawed • Dose: Adult: One dose: 8 -10 bags (10 -20 at one time) Children: 1 -2 bags/10 Kg • One dose increases the Fibrinogen by 5 -10 mg/d. L in an average -size adult • In bleeding patient, target fibrinogen is at least 100 mg/d. L
 INDICATIONS FOR CRYO • Hypofibrinogenemia or dysfibrinogenemia with active bleeding or undergoing an invasive procedure etc • < 100 mg/d. L in patient with ongoing bleeding or • < 125 mg/d. L in massive hemorrhage • FXIII deficiency with active bleeding or undergoing an invasive procedure • Uremia
INDICATIONS FOR CRYO • Hypofibrinogenemia or dysfibrinogenemia with active bleeding or undergoing an invasive procedure etc • < 100 mg/d. L in patient with ongoing bleeding or • < 125 mg/d. L in massive hemorrhage • FXIII deficiency with active bleeding or undergoing an invasive procedure • Uremia
 CASE 6 • TM request: Emergent TPE for 15 yo Hispanic F diagnosed with recently diagnosed SLE who had renal bx that showed TMA • She was emergently intubated due to large pleural effusions • Oliguric, on hemodialysis Labs: • Hgb 7. 5 g/d. L, Hct 24%, platelet 90 k/micro. L • PBS: very rare schistocytes • LDH: 940 U/L • DAT negative
CASE 6 • TM request: Emergent TPE for 15 yo Hispanic F diagnosed with recently diagnosed SLE who had renal bx that showed TMA • She was emergently intubated due to large pleural effusions • Oliguric, on hemodialysis Labs: • Hgb 7. 5 g/d. L, Hct 24%, platelet 90 k/micro. L • PBS: very rare schistocytes • LDH: 940 U/L • DAT negative
 CASE 6 (CONT) Physical Exam: • VS: T 36. 7, BP 160/59, HR 92, RR 20 • General: Intubated, on ventilator • Lungs: coarse sounds throughout anterior chest • Abdomen: open, very distended, with bloody packing • Extremities: very edematous • Neuro: sedated or sleeping; Per nurse she was awake and minimally responsive one hour ago
CASE 6 (CONT) Physical Exam: • VS: T 36. 7, BP 160/59, HR 92, RR 20 • General: Intubated, on ventilator • Lungs: coarse sounds throughout anterior chest • Abdomen: open, very distended, with bloody packing • Extremities: very edematous • Neuro: sedated or sleeping; Per nurse she was awake and minimally responsive one hour ago

 CASE 6 (CONT) Does the patient have TTP? • • • Fever – Yes! For the past few days. Anemia (MAHA) – Yes? Thrombocytopenia – Yes, not too significant Renal abnormalities – Yes, ARF! Neuro abnormatities – Yes! SLE/autoimmune diseases with TTP
CASE 6 (CONT) Does the patient have TTP? • • • Fever – Yes! For the past few days. Anemia (MAHA) – Yes? Thrombocytopenia – Yes, not too significant Renal abnormalities – Yes, ARF! Neuro abnormatities – Yes! SLE/autoimmune diseases with TTP
 CASE 6 (CONT) • TPE performed daily for a week • LDH decreased to 166, PBS: no schistocytes • Platelet count normalized However… • Hgb/Hct – seasaw pattern; transfused daily 2 -3 units of RBC • Developed abdominal compartment syndrome – Taken to the OR • R nephrectomy was performed for uncontrolled bleeding • Continued to profusely bleed intraabdominally with 2 -3 L blood collected per day from her low-vac pump • Labs: PTT = 60, F VIII < 10%, F VIII inhibitor present Follow-up: • Continue transfusion support, repeat factor VII! Stop/postpone apheresis until the life-theratening bleeding is controlled.
CASE 6 (CONT) • TPE performed daily for a week • LDH decreased to 166, PBS: no schistocytes • Platelet count normalized However… • Hgb/Hct – seasaw pattern; transfused daily 2 -3 units of RBC • Developed abdominal compartment syndrome – Taken to the OR • R nephrectomy was performed for uncontrolled bleeding • Continued to profusely bleed intraabdominally with 2 -3 L blood collected per day from her low-vac pump • Labs: PTT = 60, F VIII < 10%, F VIII inhibitor present Follow-up: • Continue transfusion support, repeat factor VII! Stop/postpone apheresis until the life-theratening bleeding is controlled.
 CASE 6 (CONT) Summary: • 15 yo H F with SLE/autoimmune disease had a renal bx • Bled intraabdominally – continuous intraabdominal bleeding profusely and renal hematoma -> abdominal compartment syndrome -> exploration with R nephrectomy • TTP improving on daily TPE • Newly developed antibody against Factor VIII while on TPE complicated the bleeding • Successfully treated with Factor VII and factor VIII + IVIG • Gradually decreased abdominal bleeding • Surgical closure of abdomen was possible • Patient was d/c from ICU, extubated, stable Hgb/Hct, creatinine decreased, discharged
CASE 6 (CONT) Summary: • 15 yo H F with SLE/autoimmune disease had a renal bx • Bled intraabdominally – continuous intraabdominal bleeding profusely and renal hematoma -> abdominal compartment syndrome -> exploration with R nephrectomy • TTP improving on daily TPE • Newly developed antibody against Factor VIII while on TPE complicated the bleeding • Successfully treated with Factor VII and factor VIII + IVIG • Gradually decreased abdominal bleeding • Surgical closure of abdomen was possible • Patient was d/c from ICU, extubated, stable Hgb/Hct, creatinine decreased, discharged
 SUMMARY • Transfusion of blood component in clinical setting follows a complex dynamics • Knowledge of clinical history is critical • Decision-making process is based on both clinical history and accurate interpretation of laboratory data • Appropriate transfusion therapy = right product and dose, for the indication, at the right time
SUMMARY • Transfusion of blood component in clinical setting follows a complex dynamics • Knowledge of clinical history is critical • Decision-making process is based on both clinical history and accurate interpretation of laboratory data • Appropriate transfusion therapy = right product and dose, for the indication, at the right time
 THANK YOU!
THANK YOU!


